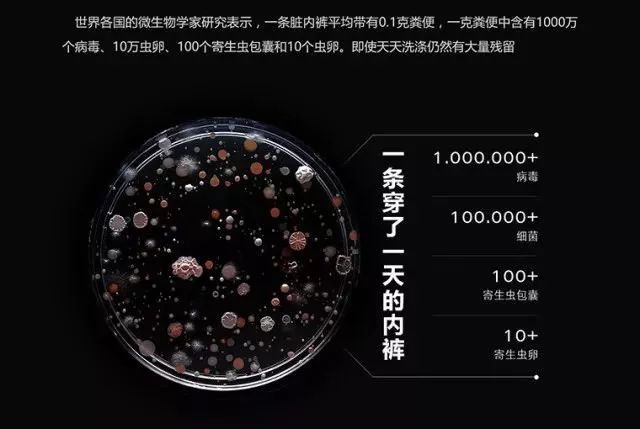
夏季超薄透气冰感收腹裤,冰感收腹提臀安全裤

初夏刚到,大家都还没来得及露腿,71岁的Vera Wang(王薇薇)就直接美爆了热搜。

在ins上传的几张自己的近照,纤细身段、修长美腿,愣是把微博和朋友圈都炸了~

网友瞬间都柠檬精附体啊,再次成为励志达人,放下手中的饮料,离开沙发座位,立刻站起来运动。

71岁啊,姐妹们,这身材一点古稀之年的样子都没有,简直是奇迹吧~

试问这紧致、挺翘的身材,哪个姑娘不羡慕呢?!
可理想很丰满,现实太骨感。对于久坐族来说,天天趴在电脑前根本没时间运动,低下头看看自己的“游泳圈”,真的是辣眼睛...
更可怕的是生完娃的妈妈,生孩子时盆骨被撑开,肚皮被撑大,加上各种激素紊乱,产后身材真的很难恢复~

运动并不能立竿见影啊,那我们只能依靠一些外界的力量,来达到视觉上“纤体”的效果,比如选购一款好的收腹裤...
喏,就是这条“薄荷裤”!

薄荷裤其实是一款收腹裤,根据人体腰部、臀部、腿部的线条设计,科学分压,贴身但不束缚,紧实而不扎肉。

千万别眨眼睛!穿上1秒,就能让整个人看上去像瘦了10斤,小肚腩没了,腰也细了~
而且它采用的是意大利裸氨面料,透气性强,穿上还有点冰冰凉的感觉,一年四季都可以穿。

1 秒拥有“薇式身材” 翘臀、蜂腰立马都有了
身边好几个同事都去试穿了一下,反馈效果特好,小肚腩不见了,屁股也翘了~

@coco:试穿的时候我刚吃过饭,完全不勒!没有任何压力感,更加不会有喘不上气的感觉,反而会因为穿了它更加挺胸抬头,气质也up up!

@Sarah:真的不会勒,之前穿牛仔裤肉肉会挤出来,穿上薄荷裤后可以把肉肉收紧。

另外,TA不仅能瘦腰,品牌根据3D人体学结构设计,能有效紧致臀部曲线,穿上臀线提升2-3CM,解决了上班族假胯宽、臀部扁平等问题~

腹部平坦、臀部上翘,体态看上去更年轻,不用节食、运动你也能拥有“薇式身材”~

智能黑科技面料 降温、清爽、 透气又养肤
小编在遇到冰冰裤之前,买过很多收腹裤塑型衣,直观的感受就是厚重闷热,不透气,穿久了会有皮肤瘙痒的问题。

而这款薄荷裤,严选优质意大利裸氨面料~

与普通塑身裤的尼龙面料不同,它更轻薄、透气,穿上有冰冰凉的感觉,超舒服!

而且面料中采用缓释微胶囊技术,将薄荷精油分解成微胶囊形式与纤维融合~

当肌肤接触摩擦面料时,面料中的冰凉薄荷精油会释放出来,一穿就凉,瞬间降温5°!

冰爽凉感的同时,还会散发水分,抑制细菌,吸收衣物中多余湿气排到体外,保持肌肤持久凉爽不闷热。

这种面料耐穿不起球,用毛刷反复摩擦面料也没有丝毫的勾丝、起球的情况,一条99元的塑身裤,质量好到超出想象!

不仅如此,面料中还添加了玻尿酸微胶囊,夏天能给肌肤源源不断的输*养送**分。

穿上后像在无时无刻给腰部敷面膜。长时间穿妊娠纹、肥胖纹、鸡皮肤都能改善。

意大利无缝编织技术 高弹力不勒人
塑形效果那么好,很多人会怀疑其穿着感。真的不会勒着难受吗?
答案是:比你穿无痕*裤内**还舒服!薄荷裤采用意大利无缝编织工艺,一体成型。独特的织法不会产生过多的束缚感,24小时穿着都不成问题。

而且腰部采用加压收腹设计,4根记忆软骨条,能帮助腹部收脂,改善腹部脂肪的循环。

三维高腰设计能加强收腹束腰,在舒适的状态下让小肚腩平坦。

同时能牢牢固定腰部,穿久了都不会出现滑落的现象。
即便进行剧烈运动,怎么跳怎么high,也能使身材“固定”住,让慵懒的小肚腩服服帖帖~~

弹力也超级棒,经过多次拉伸测试,能达到2倍长。不管是100斤带点小肚腩,还是160斤丰满体型的妹纸都能塞进去。

自从发现了这条薄荷裤,我就经常把它穿在高腰裤、连衣裙里面,连一些紧身的裙子也敢往身上套了。穿上腰围立刻减掉8cm!

石墨烯抑菌裆部 收腹裤,也是高质量安全裤
我们都知道,*裤内**是每个人的贴身衣物,穿不对容易引发妇科病。

小编以前买过价格不便宜的收腹裤,那面料摸起来不怎么地,僵硬、闷热,穿一会儿就透不过气来,夏天大量的汗液、尿液都成了病毒、细菌滋生的重灾区。
而这款薄荷裤不仅可以当做安全裤穿,还可以当*裤内**穿哦!

裆部特别采用抗菌石墨烯面料。石墨烯又被称为“黑金,具有“破坏细菌的细胞膜,从而灭杀细菌”的作用,比普通的*裤内**还要强百倍!

数据证明:对常见细菌的抑菌率到达90%以上!

你们要的检测报告在这里:

夏天穿上,都没有那种黏润感,明显感到“比穿*裤内**更舒服了”。长度也刚刚好,穿短裙不会露出,也不至于短到保护不了我们的皮肤。

而且它有天然植物活性染色工艺,哪怕是首次清洗也完全不掉色~

负氧离子温变技术 暖宫又能护肾
不仅如此,薄荷裤的腰腹部还加入了负氧离子温变技术,遇温会变色释放出负氧离子,起到暖宫护腰,增加血液循环的作用。

夏天穿可以很好地护胃暖宫,防止空调房的冷空气入侵。宫暖了,痛经啊、宫寒之类的问题自然没了。

我们再来看看细节:
薄荷裤锁边走线非常工整,采用无痕锁边工艺,柔软亲肤,隐形防滑。

红豆杉树叶蕾丝花边不易卷边,当打*裤底**穿也不用担心也不怕露边。

腰部印有M/L的字样,80斤到160斤的小仙女都可以穿。

这款收腹裤有 黑色 和 肤色,大家可以根据喜好购买~

而且现在购买只要99元/条,还有买二送一限时活动,198元/3条!小编平时买三条*裤内**都要这个价格了~

有了TA,夏季穿衣服再也不怕会显胖了,瘦腰、收腹、提臀,平常出门还能充当安全裤。你离71岁王薇薇的身材就差一条薄荷裤!

▼
